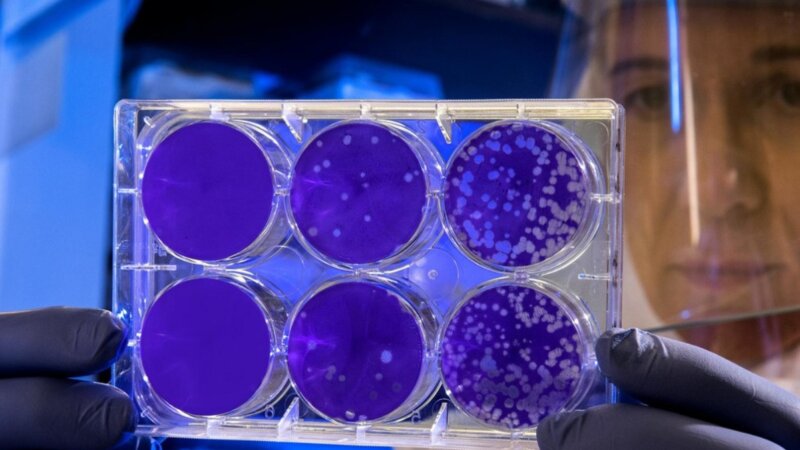

Таяние ледников, спровоцированное глобальным потеплением, может вновь пробудить неизвестные вирусы, что вызовет неожиданные последствия для человечества. Об этом рассказал лауреат нобелевской премии мира 2007 года Рэй Квон Чунг.
«Невозможно предсказать, какие вирусы, существовавшие в доисторическую эпоху или тысячи лет назад, могут появиться снова. Я уверен, что есть разные типы вирусов, с которыми мы никогда раньше не сталкивались», — отметил эксперт.
По его словам, одной из зон риска может стать российская Сибирь. Из-за таяния льдов в тайге и тундре наружу могут выйти древние вирусы, которые спали в вечной мерзлоте тысячи лет.
Раэ Квон Чунг подчеркнул важность подготовки человечества к противодействию этим вызовам и быстрому реагированию. Он отметил, что угрозу необходимо устранять совместными усилиями всего международного сообщества. «Я не думаю, что этого можно достичь простым сотрудничеством арктических государств, поскольку все происходит из-за выбросов углерода во всем мире. Я думаю, что важно приложить усилия в глобальном, а не в местном масштабе», — добавил он.